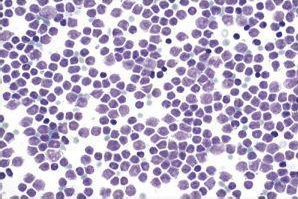

【本文為疾病百科知識(shí),僅供閱讀】 2017-12-26 作者:厚樸方舟
霍奇金淋巴瘤(Hodgkin Lymphoma),曾被稱為霍奇金氏病,何杰金氏病,或何杰金氏淋巴瘤。它是源于淋巴細(xì)胞的一種癌變?!盎羝娼稹钡拿窃从赥homas Hodgkin在1832年前列個(gè)描述了這種淋巴系統(tǒng)獨(dú)特的惡性疾病。它常開始發(fā)生于一組淋巴結(jié),然后擴(kuò)散到其他淋巴結(jié)或結(jié)外器官、組織。其組織病理學(xué)特征為惡性Reed-Sternberg(里-斯)細(xì)胞的出現(xiàn)。目前,化療、放療和骨髓移植在
霍奇金淋巴瘤治療上的應(yīng)用,使它已經(jīng)成為可以痊愈的腫瘤。
?
?
"復(fù)發(fā)和難治性霍奇金淋巴瘤
如果您的霍奇金淋巴瘤在前幾次治療后并沒有好轉(zhuǎn),那就稱為難治性。醫(yī)生可能會(huì)介紹多種治療方案,用于治療已復(fù)發(fā)(復(fù)發(fā))的難治性淋巴瘤或淋巴瘤。這些包括化療,放療,新藥和干細(xì)胞移植。
?
MSK的專家已經(jīng)率先獲得FDA批準(zhǔn)復(fù)發(fā)和難治性霍奇金淋巴瘤的救命和新型治療方法。
?
一種這樣的治療是brentuximab vedotin(Adcetris)。FDA在2011年批準(zhǔn)了霍奇金淋巴瘤的這種藥物。它與霍奇金淋巴瘤腫瘤細(xì)胞表面的蛋白質(zhì)結(jié)合并殺死細(xì)胞。
?
霍奇金淋巴瘤的免疫治療方法方法方法
其他新的治療方法是免疫治療方法方法方法藥物nivolumab(opdivo?)和pembrolizumab(Keytruda?)。它們都是檢查點(diǎn)抑制劑,它們阻斷T細(xì)胞表面的特定蛋白質(zhì)。通常你的身體的免疫系統(tǒng)使用T細(xì)胞來幫助抵抗你體內(nèi)癌癥的發(fā)展。檢查點(diǎn)抑制劑釋放免疫系統(tǒng)的自然剎車,使T細(xì)胞攻擊癌癥。
?
MSK的研究人員在霍奇金淋巴瘤免疫治療方法方法方法藥物的開發(fā)和測試中發(fā)揮了先驅(qū)作用。事實(shí)上,我們的研究人員領(lǐng)導(dǎo)了國際臨床試驗(yàn),導(dǎo)致nivolumab和pembrolizumab 被批準(zhǔn)用于已經(jīng)用盡所有其他治療的患者。
?
干細(xì)胞移植
治療霍奇金淋巴瘤
干細(xì)胞移植可以痊愈初始治療后復(fù)發(fā)的霍奇金淋巴瘤。具體而言,通常介紹使用患者自身干細(xì)胞的自體干細(xì)胞移植。
?
MSK是 霍奇金淋巴瘤血液和骨髓干細(xì)胞移植領(lǐng)域中經(jīng)驗(yàn)較豐富的中心之一。
?
霍奇金淋巴瘤的臨床試驗(yàn)
研究人員不斷運(yùn)行臨床試驗(yàn) ?來改善霍奇金淋巴瘤患者的治療方案。我們正在研究新藥是否可以不受威脅有效地與化療,放療和干細(xì)胞移植聯(lián)合使用,以提高新診斷,復(fù)發(fā)和難治性霍奇金淋巴瘤患者的五年生存率。"
?
?
厚樸方舟2012年進(jìn)入海外醫(yī)療領(lǐng)域,總部位于北京,建立了由全球權(quán)威醫(yī)學(xué)專家組成的美日名醫(yī)集團(tuán),初個(gè)擁有日本政府官方頒發(fā)的海外醫(yī)療資格的企業(yè)。如果您有海外就醫(yī)的需要,請(qǐng)撥打免費(fèi)熱線進(jìn)行咨詢!
本文由厚樸方舟編譯,版權(quán)歸厚樸方舟所有,轉(zhuǎn)載或引用本網(wǎng)版權(quán)所有之內(nèi)容須注明"轉(zhuǎn)自厚樸方舟官網(wǎng)(www.wyaoyao.cn)"字樣,對(duì)不遵守本聲明或其他違法、惡意使用本網(wǎng)內(nèi)容者,本網(wǎng)保留追究其法律責(zé)任的權(quán)利。
上一篇:出國看?。好绹绾沃委煼腔羝娼鹆馨土??--紀(jì)念斯隆凱特林癌癥中心
下一篇:出國看?。好绹绾沃委熁准?xì)胞瘤?